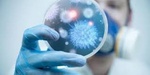

Новини проекту
Новий навчальний рік!
Спільноті адміністраторів сайтів шкіл та ліцеїв!
Новий навчальний рік!
Найзахопливіші детективи для підлітка
Wizeclub Education: курси додаткової освіти в Україні
Що робити, якщо болить поперек
Онлайн академія Mate academy – від мрії потрапити в IT до першої роботи
Мобільні додатки для підтримки організації навчання та співпраці в освітньому процесі
Школа англійської для дітей: важливість навчання та як вибрати кращу школу
Хто такий Зевс?
Вивчаємо англійську за допомогою читання
Благодійність та соціальна відповідальність бізнесу
Як обрати надувний басейн?
Як створити і розкрутити групу у Фейсбуці без блокування
Практичні рекомендації по вибору школи англійської мови
Options for checking articles and other texts for uniqueness
Різниця між Lightning та USB Type-C: одна з відмінностей iPhone
Столична Ювелірна Фабрика
Відеоспостереження у школі: як захистити своїх дітей?
Чим привабливий новий Айфон 14?
Розширений пакет за акційною ціною!
iPhone 11 128 GB White
Програмування мовою Java для дітей — як батьки можуть допомогти в навчанні
Нюанси пошуку репетитора з англійської мови
Плюси та мінуси вивчення англійської по Скайпу
Роздруківка журналів
Either work or music: 5 myths about musicians and work
На лижі за кордон. Зимові тури в Закопане
Яку перевагу мають онлайн дошки оголошень?
Огляд смартфону Самсунг А53: що пропонує південнокорейський субфлагман
БЕЗПЕКА В ІНТЕРНЕТІ
Вітаємо з Днем Вчителя!
Портал E-schools відновлює роботу
Канікули 2022
Підписано меморандум з Мінцифрою!
Профілактика інфекційних захворювань
У класах гімназії обговорили тему захисту себе від ГРВ. Профілактика інфекційних захворювань — це сукупність заходів, спрямованих на ізоляцію хворих, розрив механізму передачі хвороби та формування несприйнятливості до збудників захворювання оточуючих Вас людей.
Профілактику інфекційних хвороб слід проводити шляхом знешкодження джерела інфекції, ліквідацією або розривом її розповсюдження, а також впливаючи на сприйнятливий організм людини з метою створення імунітету.
Коментарі:
Залишати коментарі можуть тільки авторизовані відвідувачі.